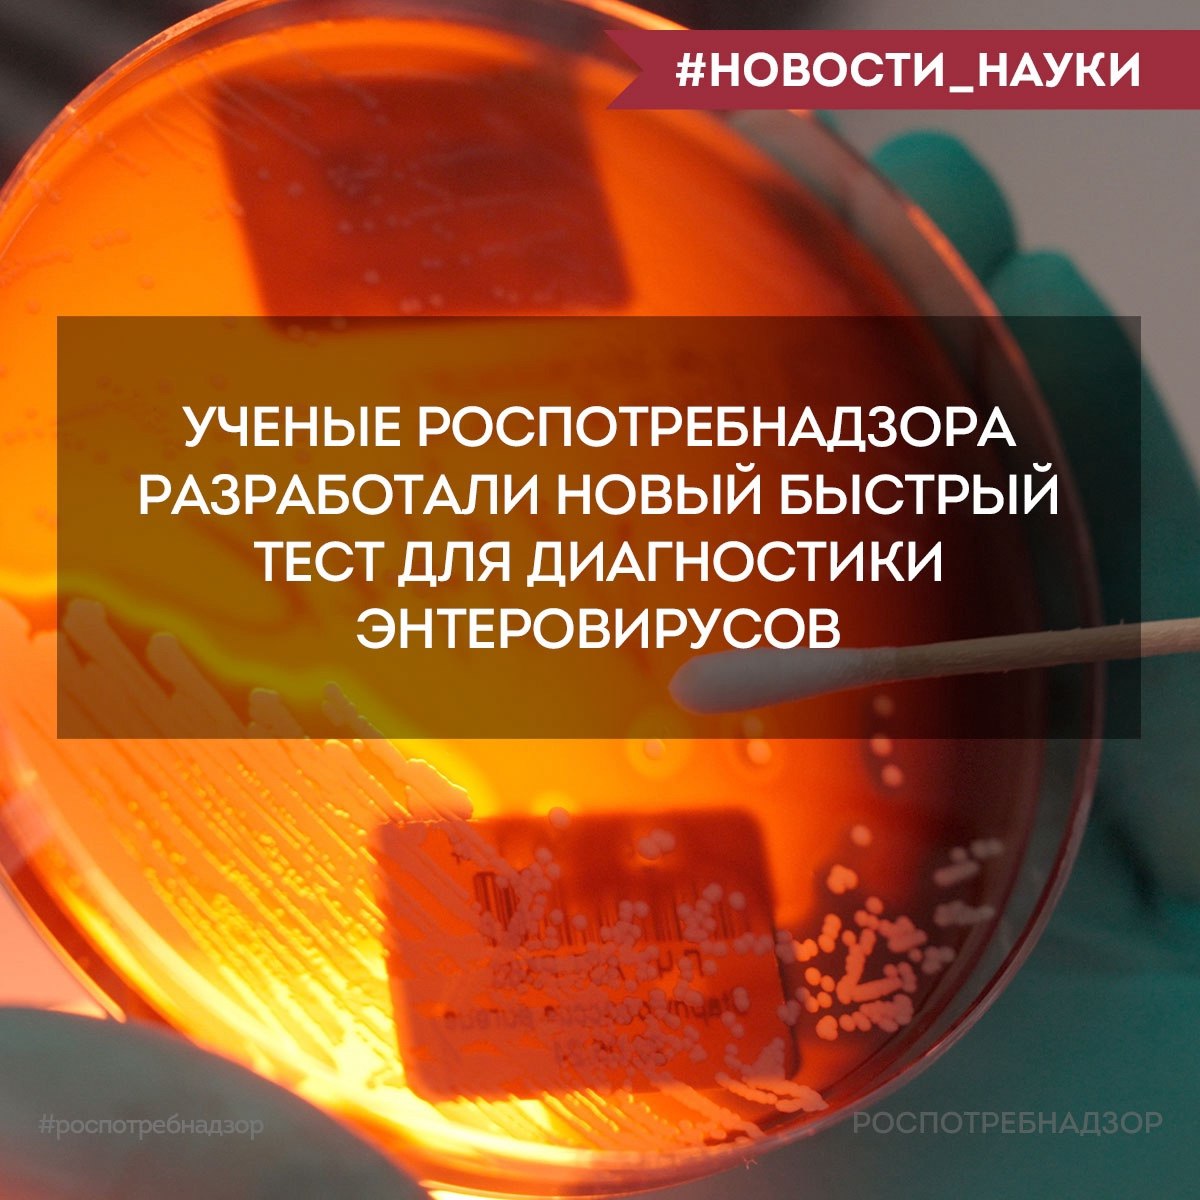

16 октября, 13:09
Новый тест Роспотребнадзора для диагностики энтеровирусов сокращает время анализа до 30 минут


Кратко
Ученые Роспотребнадзора разработали новый тест для диагностики энтеровирусов Ученые ЦНИИ Эпидемиологии Роспотребнадзора разработали новый тест для определения энтеровирусов сообщили в пресс службе службы в четверг Новый тест позволяет всего за 30 минут проводить мониторинг окружающей среды на наличие этих возбудителей что значительно быстрее традиционных методов диагностики

Новости Роспотребнадзора
Роспотребнадзор VK Ученые ЦНИИ Эпидемиологии Роспотребнадзора разработали новый быстрый тест для диагностики энтеровирусов Энтеровирусы представляют собой группу вирусов способных вызывать разнообразные заболевания от легких респираторных и желудочно кишечных инфекций до серьезных состояний связанных с поражением центральной нервной системы Эти вирусы могут сохраняться в окружающей среде в том числе в сточных водах Новый тест позволяет всего за 3 0 минут проводить мониторинг окружающей среды на наличие этих возбудителей что значительно быстрее традиционных методов диагностики Он также обладает высокой специфичностью что критически важно для эпидемиологического надзора Разработка была осуществлена в рамках Федерального проекта Санитарный щит страны безопасность для здоровья предупреждение выявление реагирование

Лаборатория Z
Ученые ЦНИИ Эпидемиологии Роспотребнадзора разработали новый тест для определения энтеровирусов сообщили в пресс службе службы в четверг Новый тест позволяет всего за 30 минут проводить мониторинг окружающей среды на наличие этих возбудителей что значительно быстрее традиционных методов диагностики

Новости Роспотребнадзора
Ученые Роспотребнадзора разработали новый тест для диагностики энтеровирусов 16 октября INTERFAX RU Ученые ЦНИИ Эпидемиологии Роспотребнадзора разработали новый тест для определения энтеровирусов сообщили в пресс службе службы в четверг Новый тест позволяет всего за 30 минут проводить мониторинг окружающей среды на наличие этих возбудителей что значительно быстрее традиционных методов диагностики Кроме того тест отличается высокой специфичностью что крайне важно для эпидемиологического надзора за энтеровирусными инфекциями говорится в сообщении Там отмечается что разработка была осуществлена в рамках федерального проекта Санитарный щит страны безопасность для здоровья предупреждение выявление реагирование В Роспотребнадзоре напомнили что энтеровирусы представляют собой группу вирусов способных вызывать разнообразные заболевания от легких респираторных и желудочно кишечных инфекций до серьезных состояний связанных с поражением центральной нервной системы Эти вирусы могут сохраняться в окружающей среде в том числе в сточных водах

Dagpravda | Здоровье
Ученые ЦНИИ Эпидемиологии Роспотребнадзора разработали новый быстрый тест для диагностики энтеровирусов Энтеровирусы представляют собой группу вирусов способных вызывать разнообразные заболевания от легких респираторных и желудочно кишечных инфекций до серьезных состояний связанных с поражением центральной нервной системы Эти вирусы могут сохраняться в окружающей среде в том числе в сточных водах Новый тест позволяет всего за 30 минут проводить мониторинг окружающей среды на наличие этих возбудителей что значительно быстрее традиционных методов диагностики Он также обладает высокой специфичностью что критически важно для эпидемиологического надзора
Похожие новости



+6



+24



+8



+3






+3

Курган и Магадан присоединились к Всероссийской акции по тестированию на ВИЧ
Происшествия
11 часов назад


+6
Роспотребнадзор определил регионы с высоким риском клещевого энцефалита
Происшествия
1 день назад


+24
В Красноярском крае введен режим повышенной готовности из-за вспышки пастереллеза
Происшествия
1 день назад


+8
Россияне смогут оформлять гражданство детей через Госуслуги с 2026 года
Политика
15 часов назад


+3
Итоги нацпроекта 'Продолжительная и активная жизнь' за I квартал 2026 года
Общество
5 часов назад


Тестирование для детей мигрантов в Екатеринбурге и выпускников начальной школы в Молдове
Общество
11 часов назад


+3